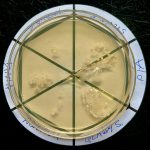
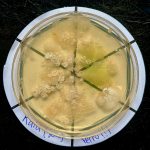
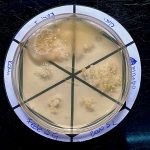
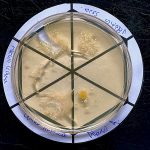
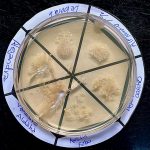
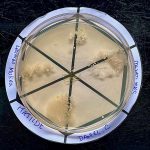
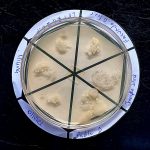
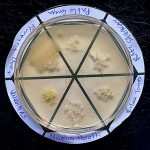
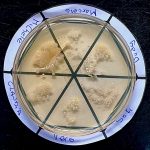
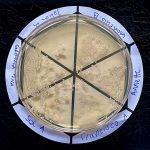
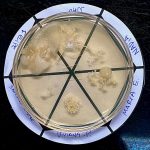

Si pasaste por el stand de la Unidad Académica de Bacteriología y Virología durante tu visita al Instituto de Higiene el Día del Patrimonio, acá vas a poder encontrar las imágenes del crecimiento de bacterias de tus dedos.













Si pasaste por el stand de la Unidad Académica de Bacteriología y Virología durante tu visita al Instituto de Higiene el Día del Patrimonio, acá vas a poder encontrar las imágenes del crecimiento de bacterias de tus dedos.